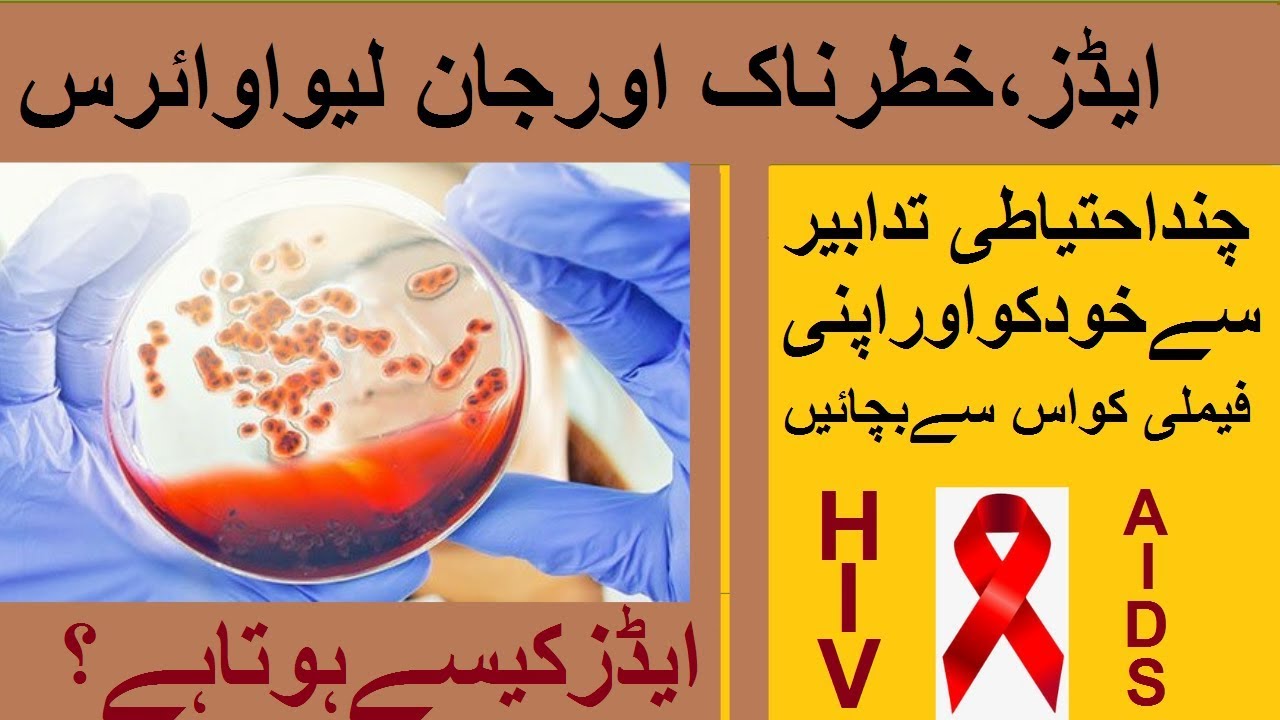
What Is HIV/Aids| Pakistan Main Aids Ki Bharti Hui Tadad| 2019 Report ...

Hiv/aids Urdu
Celebrate competition through numerous action-packed Hiv/aids Urdu photographs. competitively showcasing computer, digital, and electronic. perfect for sports marketing and media. Discover high-resolution Hiv/aids Urdu images optimized for various applications. Suitable for various applications including web design, social media, personal projects, and digital content creation All Hiv/aids Urdu images are available in high resolution with professional-grade quality, optimized for both digital and print applications, and include comprehensive metadata for easy organization and usage. Explore the versatility of our Hiv/aids Urdu collection for various creative and professional projects. Reliable customer support ensures smooth experience throughout the Hiv/aids Urdu selection process. Comprehensive tagging systems facilitate quick discovery of relevant Hiv/aids Urdu content. Our Hiv/aids Urdu database continuously expands with fresh, relevant content from skilled photographers. Cost-effective licensing makes professional Hiv/aids Urdu photography accessible to all budgets. Regular updates keep the Hiv/aids Urdu collection current with contemporary trends and styles. The Hiv/aids Urdu collection represents years of careful curation and professional standards. Multiple resolution options ensure optimal performance across different platforms and applications. Time-saving browsing features help users locate ideal Hiv/aids Urdu images quickly. Each image in our Hiv/aids Urdu gallery undergoes rigorous quality assessment before inclusion.